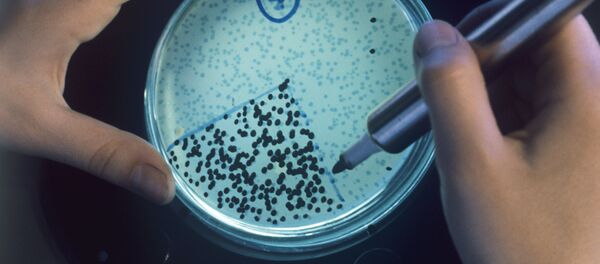
Etude - Sputnik Afrique

Des chercheurs de l’Université nationale de recherche et de technologie MISiS ont conçu, en collaboration avec des collègues russes, tchèques et américains, un nouveau matériau destiné aux implants prévenant le développement de la contamination bactériologique après une opération chirurgicale. Grâce à la présence de nanoparticules de platine et de fer, ce matériau est en mesure de tuer jusqu’à 98% des bactéries pendant 12 heures après l’installation de l’implant. L’article sur sa conception a été publié dans la revue Applied Materials & Interfaces.
Des chercheurs de l’Université nationale de recherche et de technologie MISiS et leurs collègues ont ainsi conçu un matériau destiné aux implants contenant des nanoparticules de métaux et supprimant efficacement l’expansion et la dissémination de bactéries pathogènes, sans opprimer les cellules du système immunitaire: les lymphocytes.
«Nous avons implanté des ions de platine et de fer dans la matrice, qui est une couche céramique biocompatible TiCaPCON (titane-calcium-phosphore-carbone-oxygène-azote). On a constaté en résultat la formation de nanoparticules des métaux - de plusieurs nanomètres de taille - à la surface de la couche. Cela forme un potentiel électrique d’environ 60 mW entre les nanoparticules et la matrice céramique. Une bactérie peut se détruire en contactant la surface du matériel», explique Viktor Ponomarev, auteur en chef de l’étude, doctorant de la chaire des métaux poudreux et des couches fonctionnelles de l’Université nationale de recherche et de technologie MISiS.
Selon les auteurs de l’étude, lors des expériences leur matériau a réussi à tuer pendant 8 à 12 heures 98% des bactéries, notamment le staphylocoque doré et épidermique, le bacille intestinal ou le pneumobacille. Aujourd’hui, les scientifiques étudient la possibilité de tester les échantillons in vivo. Une autre utilisation prometteuse du matériau conçu pourrait être la création de filtres à eau.